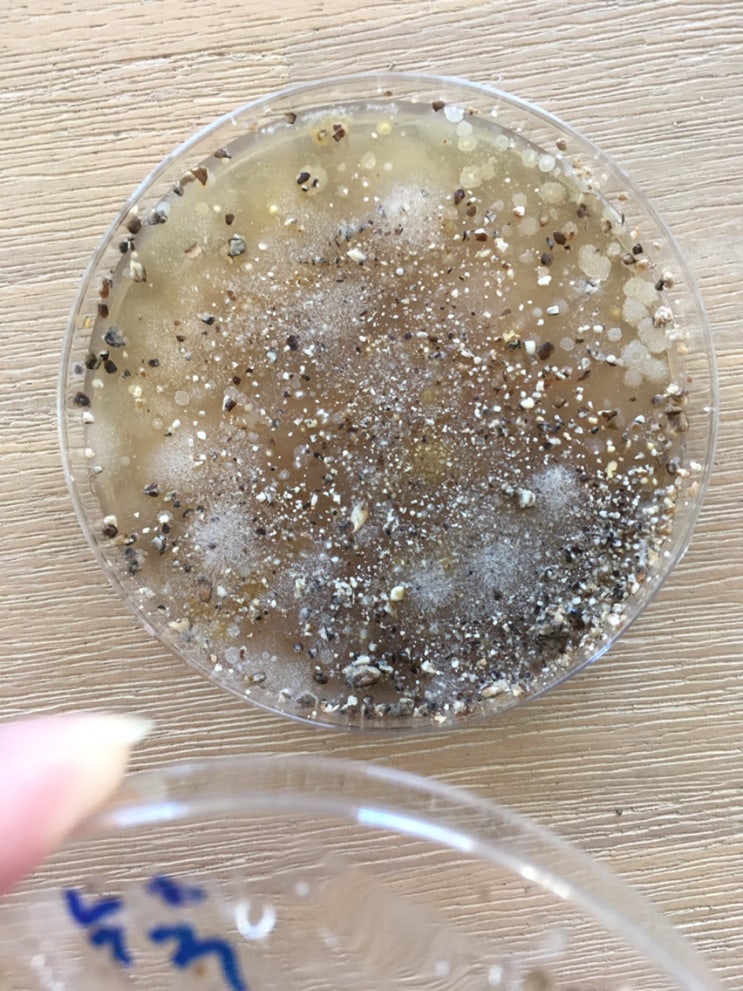

23년 4월 2일의 홍성 서부면 산불때문에 타버린 청룡산 산행
2025.03.14

강아지들과 엄마와 함께 불이 났었던 서부면과 결성면 경계의 우리집 뒷산 청룡산에 올라가 보았다. 중간정...
출처
https://blog.naver.com/wlsqo7/223113265214
이슈모어 핫이슈
관련 포스팅
Copyright blog.dowoo.me All right reserved.